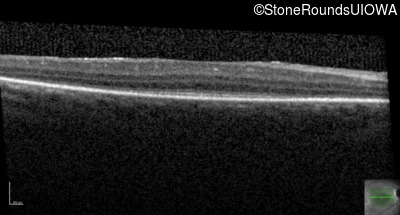
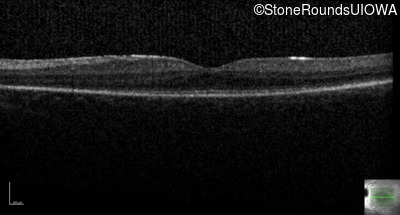
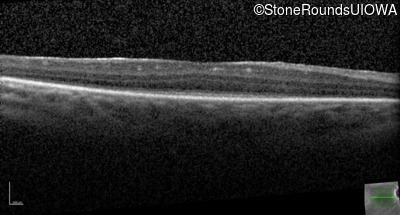
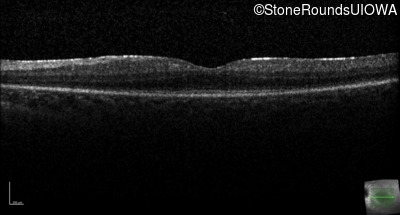
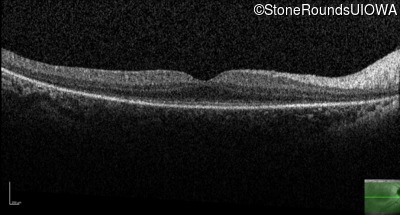
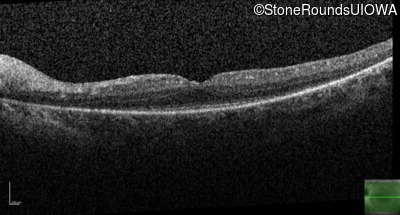

Case
SR26
Student Mode
Syndromic Photoreceptor Disease (IB)
Male
Male
Hidden
SR26
Student Mode
Syndromic Photoreceptor Disease (IB)
Male
Male
History
This 13 year old male has been night blind for his entire life. He has a significant pectus excavatum.
| Age at visit: 13 years |
| Age at visit: 14 years |
Diagnosis & molecular findings
| Disease | Gene | Allele 1 variant(s) | Allele 2 variant(s) | Inheritance mode |
|---|---|---|---|---|
| Syndromic Photoreceptor Disease | WDR19 | Leu710Ser TTG>TCG | Arg1022 del2agAT | AR |
Disease:
Gene:
Allele 1:
Leu710Ser TTG>TCG
Allele 2:
Arg1022 del2agAT
Inheritance:
AR